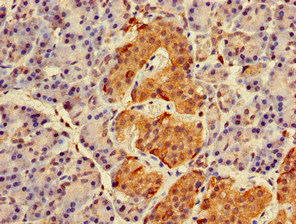
CSB-PA019177LA01HU

RAB27A
RAB27A,全稱為Ras相關蛋白Rab-27A,常用別名有Rab27、MSP等。它是細胞內囊泡運輸的關鍵參與者,能調控囊泡與靶膜的錨定或融合,介導黑色素小體分泌、免疫細胞顆粒釋放等生理過程——比如黑色素細胞中,它幫助黑色素小體到達細胞膜并釋放色素,若這一過程異常會影響皮膚毛發的顏色。
RAB27A突變時,可能引發格里塞利綜合征2型,患者常出現皮膚毛發色素變淺、免疫功能低下,部分還伴有神經系統損傷。在乳腺癌、肺癌等腫瘤中,該蛋白表達常異常升高,通過促進腫瘤外泌體釋放增強癌細胞侵襲轉移能力。目前針對其在腫瘤中的作用,科研人員正探索靶向抑制的小分子化合物,部分候選藥物處于早期實驗室研究階段,有望為相關疾病治療提供新方向。
熱銷產品
Recombinant Human Ras-related protein Rab-27A (RAB27A) (CSB-YP019177HU)
驗證數據

(Tris-Glycine gel) Discontinuous SDS-PAGE (reduced) with 5% enrichment gel and 15% separation gel.
RAB27A Recombinant Monoclonal Antibody (CSB-RA285197A0HU)
驗證數據

Overlay Peak curve showing PC3 cells stained with CSB-RA285197A0HU (red line) at 1:100. The cells were fixed in 4% formaldehyde and permeated by 0.2% TritonX-100. Then 10% normal goat serum to block non-specific protein-protein interactions followed by the antibody (1ug/1*106cells) for 45min at 4℃. The secondary antibody used was FITC-conjugated Goat Anti-rabbit IgG(H+L) at 1:200 dilution for 35min at 4℃.Control antibody (green line) was rabbit IgG (1ug/1*106cells) used under the same conditions. Acquisition of >10,000 events was performed.
RAB27A Antibody (CSB-PA019177LA01HU)
驗證數據
Immunohistochemistry of paraffin-embedded human pancreatic tissue using CSB-PA019177LA01HU at dilution of 1:100

Immunohistochemistry of paraffin-embedded human spleen tissue using CSB-PA019177LA01HU at dilution of 1:100

Immunofluorescent analysis of HepG2 cells using CSB-PA019177LA01HU at dilution of 1:100 and Alexa Fluor 488-congugated AffiniPure Goat Anti-Rabbit IgG(H+L)
RAB27A Antibodies
RAB27A for Homo sapiens (Human)
| 產品貨號 | 產品名稱 | 種屬反應性 | 應用類型 |
|---|---|---|---|
| CSB-PA019177GA01HU | RAB27A Antibody | Human,Mouse,Rat | ELISA,WB,IHC,IF |
| CSB-PA660209 | RAB27A Antibody | Human,Mouse,Rat | ELISA,WB,IHC |
| CSB-PA946810 | RAB27A Antibody | Human,Mouse,Rat | ELISA,WB,IHC |
| CSB-PA019177LA01HU | RAB27A Antibody | Human | ELISA, IHC, IF |
| CSB-PA019177LB01HU | RAB27A Antibody, HRP conjugated | Human | ELISA |
| CSB-PA019177LC01HU | RAB27A Antibody, FITC conjugated | Human | |
| CSB-PA019177LD01HU | RAB27A Antibody, Biotin conjugated | Human | ELISA |
| CSB-RA285197A0HU | RAB27A Recombinant Monoclonal Antibody | Human | ELISA, FC |
| CSB-MA925178 | RAB27A Monoclonal Antibody | Human, Rat | ELISA, WB |
RAB27A Proteins
RAB27A Proteins for Homo sapiens (Human)
| 產品貨號 | 產品名稱 | 來源 |
|---|---|---|
| CSB-EP019177HU CSB-BP019177HU CSB-MP019177HU CSB-EP019177HU-B |
Recombinant Human Ras-related protein Rab-27A (RAB27A) | E.coli Baculovirus Mammalian cell In Vivo Biotinylation in E.coli |
| CSB-YP019177HU | Recombinant Human Ras-related protein Rab-27A (RAB27A) | Yeast |
















